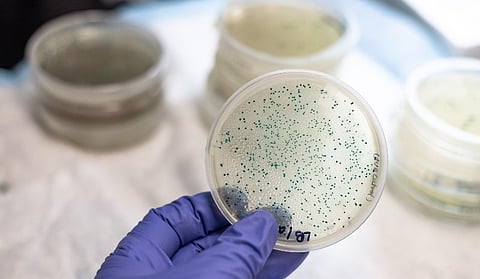

Adobe Stock
MONDAY, April 1, 2024 (HealthDay News) -- A regional collaborative involving universal decolonization in long-term care facilities and targeted decolonization among hospital patients in contact precautions is associated with better multidrug-resistant organism (MDRO)-related outcomes, according to a study published online April 1 in the Journal of the American Medical Association.
Gabrielle M. Gussin, from the University of California Irvine School of Medicine, and colleagues evaluated whether implementation of a decolonization collaborative is associated with reduced regional MDRO prevalence, incident clinical cultures, infection-related hospitalizations, costs, and deaths. The analysis included data from 35 participating facilities (16 hospitals, 16 nursing homes [NHs], and three long-term acute care hospitals [LTACHs]).
The researchers found that compared with baseline, decolonization was associated with a decrease in mean MDRO prevalence (NHs: 63.9 to 49.9 percent; LTACHs: 80.0 to 53.3 percent; odds ratio for both, 0.48; hospitalized patients in contact precautions: 64.1 to 55.4 percent; odds ratio, 0.75). Mean monthly incident MDRO clinical cultures changed from 2.7 to 1.7 among participating NHs, from 1.7 to 1.5 among nonparticipating NHs (group × period interaction reduction, 30.4 percent), and from 25.5 to 25.0 among participating hospitals and 12.5 to 14.3 among nonparticipating hospitals (group × period interaction reduction, 12.9 percent). Benefits were seen for infection-related hospitalizations, associated hospitalization costs, and associated hospitalization deaths.
"The success of SHIELD-OC [Shared Healthcare Intervention to Eliminate Life-threatening Dissemination of MDROs in Orange County] in reducing MDRO carriage, infections, hospitalizations, and associated costs and deaths led to a regional NH incentive program supported by CalOptima, the sole Medicaid provider," the authors write.
Antiseptic supplies for the study were provided by Stryker (Sage Products), Xttrium Laboratories, and Medline Industries.